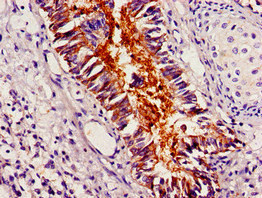

PLIN1 Antibody
-
中文名稱:PLIN1兔多克隆抗體
-
貨號:CSB-PA526447YA01HU
-
規格:¥440
-
圖片:
-
其他:
產品詳情
-
產品名稱:Rabbit anti-Homo sapiens (Human) PLIN1 Polyclonal antibody
-
Uniprot No.:
-
基因名:
-
別名:Lipid droplet associated protein antibody; Lipid droplet-associated protein antibody; PERI antibody; Perilipin A antibody; Perilipin antibody; Perilipin-1 antibody; PerilipinA antibody; PLIN antibody; PLIN1 antibody; PLIN1_HUMAN antibody
-
宿主:Rabbit
-
反應種屬:Human
-
免疫原:Recombinant Human Perilipin-1 protein (411-496AA)
-
免疫原種屬:Homo sapiens (Human)
-
標記方式:Non-conjugated
本頁面中的產品,PLIN1 Antibody (CSB-PA526447YA01HU),的標記方式是Non-conjugated。對于PLIN1 Antibody,我們還提供其他標記。見下表:
-
克隆類型:Polyclonal
-
抗體亞型:IgG
-
純化方式:>95%, Protein G purified
-
濃度:It differs from different batches. Please contact us to confirm it.
-
保存緩沖液:Preservative: 0.03% Proclin 300
Constituents: 50% Glycerol, 0.01M PBS, pH 7.4 -
產品提供形式:Liquid
-
應用范圍:ELISA, IHC
-
推薦稀釋比:
Application Recommended Dilution IHC 1:20-1:200 -
Protocols:
-
儲存條件:Upon receipt, store at -20°C or -80°C. Avoid repeated freeze.
-
貨期:Basically, we can dispatch the products out in 1-3 working days after receiving your orders. Delivery time maybe differs from different purchasing way or location, please kindly consult your local distributors for specific delivery time.
-
用途:For Research Use Only. Not for use in diagnostic or therapeutic procedures.
相關產品
靶點詳情
-
功能:Modulator of adipocyte lipid metabolism. Coats lipid storage droplets to protect them from breakdown by hormone-sensitive lipase (HSL). Its absence may result in leanness. Plays a role in unilocular lipid droplet formation by activating CIDEC. Their interaction promotes lipid droplet enlargement and directional net neutral lipid transfer. May modulate lipolysis and triglyceride levels.
-
基因功能參考文獻:
- Classification of cells as containing few large or many small LDs followed by calculating the percentage of cells in each class proved to discriminate the positive PLIN1-suppressed phenotype from the untreated negative control with an area under the receiver operating characteristic curve of 0.98. PMID: 29031005
- Expression of UCP2 and PLIN1 genes influences the resting metabolic rate in obese individuals and could predict the weight loss after bariatric surgery. PMID: 27376365
- The PLIN 6 polymorphism of the perilipin gene may influence the risk of obesity during adolescence. PMID: 28274232
- Variability at the PLIN1 locus is associated with variability in weight loss. Moreover, eating late is related to lower weight-loss effectiveness among carriers of the AA genotype at the PLIN1 14995A>T variant. PMID: 27629052
- The strong association of PLIN1, CFD and ADIPOQ genes with adipogenesis prompted authors to study the influence the bone health status as evaluated by quantitative ultrasound (QUS) bone densitometer in a North Indian cohort. Overall, ADIPOQ (rs1501299 and rs3774261) and combined cluster of PLIN1 rs2304796 and rs2304795) and CFD (rs1683563) demonstrated correlation. PMID: 28189761
- Perilipin 1 expression increased with adipocytic differentiation of liposarcoma subtypes showing statistical significance. PMID: 27646609
- Based on the PCR with mismatched primers PLIN1 polymorphisms could be identified effectively in Chinese Han population. PMID: 27468581
- Conserved amphipathic helices mediate lipid droplet targeting of PLIN1, PLIN2, and PLIN3. PMID: 26742848
- Skeletal muscle PLIN proteins likely play a role in the hydrolysis of triglycerides stored in lipid droplets and the passage of fatty acids to the mitochondria for oxidation. PMID: 25971423
- The functional PLIN1 rs6496589 may influence the risk of central obesity through possible regulation of lipid storage. PMID: 25529448
- After bariatric surgery-induced weight loss, PLIN1 gene/protein expression in SAT increased significantly. Findings suggest a positive functional interaction between PLIN1 & mitochondrial biogenesis-related genes in human adipose tissue. PMID: 24126816
- Use of molecular docking software to design perilipin-1 inhibitors as antiobesity agents. PMID: 24610610
- This plin1 variant binds and stabilizes ABHD5 expression but still fails to inhibit basal lipolysis as effectively as wild-type perilipin 1. PMID: 25114292
- In long-term steatosis models in vitro, TIP47, MLDP, adipophilin, and finally perilipin were gradually induced PMID: 24269473
- Independently and in an interactive manner, PLIN (and ENPP1) contribute to the risk of type 2 diabetes in a Taiwanese population. PMID: 23111648
- Chinese adults with high waist circumference may have a high risk of diabetes, especially those with allele T in rs1052700 or with allele A in rs894160 of perilipin gene and those with perilipin genotype AA (rs894160) may have a high risk of obesity. PMID: 23517113
- Although specific for invasive sebaceous carcinoma, perilipin expression was not helpful in distinguishing sebaceous carcinoma in situ from squamous cell carcinoma in situ with clear cell change. PMID: 23642680
- Perilipin is almost exclusively expressed in white adipocytes, so the serious metabolic sequelae observed in patients suggest that primary defects in adipose tissue can lead to all the typical features seen in patients with the metabolic syndrome.[review] PMID: 23392103
- PKC activation is required for TSH-stimulated perilipin phosphorylation and lipolysis in differentiated adipocytes. PMID: 22730012
- Reduced mRNA and protein content of Plin and G0S2 and borderline increased ATGL protein in sc adipose tissue from poorly controlled type 2 diabetic subjects. PMID: 22535977
- The morning cortisol increase as indicated by CAR correlated positively and significantly with hPER1 gene expression in older women suggesting that hPER1 expression increases in response to the morning cortisol increase in older women PMID: 22580060
- genetic association studies in populations in US Midwest (MN, UT): When ratio of saturated fat to carbohydrate is high in diet, plasma insulin and insulin resistance are higher in women who are carriers of the minor allele in a PLIN1 SNP (rs894160). PMID: 21193293
- genetic association studies in obese women in Spain (gene-diet interactions): Women on reducing diet who carry 11482(G>A) A allele have lower reduction in waist circumference and greater decrease in lipid oxidation rate than non-A allele carriers. PMID: 21392418
- Identified two heterozygous frameshift mutations in the perilipin gene (PLIN1) in three families with partial lipodystrophy, severe dyslipidemia, and insulin-resistant diabetes; findings define a novel dominant form of inherited lipodystrophy. PMID: 21345103
- a novel role for perilipin expression in adipose tissue metabolism and regulation of obesity and its metabolic complications PMID: 19797618
- The present study aimed at comparing expression and subcellular distribution of perilipin and hormone-sensitive lipase in two abdominal adipose tissues of lean and obese women. PMID: 20017959
- Expression patterns of perilipin and adipophilin in nonalcoholic fatty liver disease livers vary with the size of lipid droplets PMID: 20032580
- This study found no incrased risk of obesity in Chinese Han adults with a single nucleotide polymorphism of perilipin. PMID: 20163070
- Variation in PLIN may affect glucose and lipid metabolism in women both with and without ariation in PLIN may affect glucose and lipid metabolism in women both with and without polycystic ovary syndrome. PMID: 19782423
- Perilipin could be a factor behind impaired lipolysis in insulin-resistants sconditions. PMID: 12802495
- perilipin was elevated in obese subjects, perhaps as a compensatory mechanism to limit basal lipolysis. PMID: 15001633
- Genetic variation at the perilipin (PLIN) locus is associated with obesity-related phenotypes in White women PMID: 15355432
- study suggested a significant contribution of perilipin(PLIN) polymorphism 1243 to the elevated total cholesterol (TC) levels indicating that PLIN gene may be involved in human lipid metabolism PMID: 15601966
- data support the hypothesis that the perilipin(PLIN) locus may be a significant genetic determinant for obesity risk in whites and that women are more sensitive to the genetic effects of perilipin than men PMID: 15601970
- The association of increased obesity risk and structure of PLIN gene is studied; results support the role of the PLIN locus as an ethnically dependent modulator of obesity risk in humans. PMID: 15770500
- We show the presence and induction of perilipin in atheroma. PMID: 15961705
- PLIN11482A carriers were resistant to weight loss, suggesting that this polymorphism may predict outcome of BW reduction strategies based on low-energy diets. PMID: 15985482
- Perilipin targets a novel pool of lipid droplets for lipolytic attack by hormone-sensitive lipase PMID: 16243839
- Cooperation with other transcription factors may be differentially involved in selective transactivation of the perilipin gene by different peroxisome proliferator-activated receptor subtypes. PMID: 16567422
- PLIN 11482G-->A/14995A-->T polymorphisms modulate the association between SFAs/carbohydrate in diet and insulin resistance in Asian women. PMID: 16732014
- Genetic variations in the perilipin gene can affect weight gain associated with rosiglitazone treatment in patients with type 2 diabetes. PMID: 16732015
- Results suggest that that PLIN constitutes a susceptibility locus for reduced BMD in Japanese men. PMID: 16786163
- The rs4578621 and rs894160 polymorphisms of the perilipin gene are not major genetic determinants of obesity and type 2 diabetes-related phenotypes in a random sample of French men and women. PMID: 16836753
- PLIN is a candidate gene for obesity risk in humans as well as a modulator of dietary response to therapies aimed to reduce body weight and decrease metabolic syndrome risk. [REVIEW] PMID: 17353663
- Perilipin content decreased and adipophilin increased with lipoprotein lipid loading regardless of intracellular neutral lipid composition PMID: 17927964
- negative finding that the common variants of PLIN do not have a major effect on susceptibility to stroke in a Chinese population PMID: 18174481
- The results of these studies demonstrated that A. phagocytophilum modulates lipid metabolism by increasing PLIN mRNA levels and facilitates infection of HL-60 cells. PMID: 18201980
- Thus, the perilipin gene expression is regulated by a transcriptional network controlling energy metabolism, substantiating the functional importance of perilipin in the maintenance of body energy balance. PMID: 18243128
- These 2 studies suggest that the presence of the minor C and A alleles at PLIN1 and PLIN4, respectively, are associated with a lower postprandial response that may result in lower atherogenic risk for these persons PMID: 18326614
- Central obesity may modify the associations between PLIN variations and diabetes risk in women. PMID: 18356850
顯示更多
收起更多
-
相關疾病:Lipodystrophy, familial partial, 4 (FPLD4)
-
亞細胞定位:Endoplasmic reticulum. Lipid droplet.
-
蛋白家族:Perilipin family
-
組織特異性:Detected in adipocytes from white adipose tissue (at protein level). Detected in visceral adipose tissue and mammary gland.
-
數據庫鏈接:
Most popular with customers
-
-
YWHAB Recombinant Monoclonal Antibody
Applications: ELISA, WB, IHC, IF, FC
Species Reactivity: Human, Mouse, Rat
-
Phospho-YAP1 (S127) Recombinant Monoclonal Antibody
Applications: ELISA, WB, IHC
Species Reactivity: Human
-
-
-
-
-